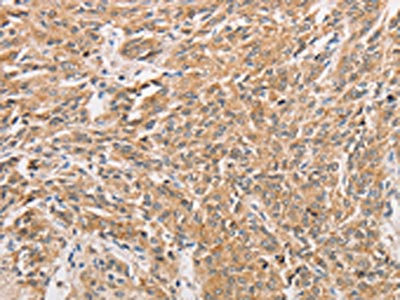

WNT11 Antibody
-
中文名稱:WNT11兔多克隆抗體
-
貨號:CSB-PA991992
-
規(guī)格:¥1100
-
圖片:
-
The image on the left is immunohistochemistry of paraffin-embedded Human thyroid cancer tissue using CSB-PA991992(WNT11 Antibody) at dilution 1/20, on the right is treated with fusion protein. (Original magnification: ×200)
-
The image on the left is immunohistochemistry of paraffin-embedded Human prostate cancer tissue using CSB-PA991992(WNT11 Antibody) at dilution 1/20, on the right is treated with fusion protein. (Original magnification: ×200)
-
-
其他:
產(chǎn)品詳情
-
Uniprot No.:
-
基因名:
-
別名:HWNT11 antibody; Protein Wnt-11 antibody; Wingless-related MMTV integration site 11 antibody; Wingless-type MMTV integration site family, member 1 antibody; Wingless-type MMTV integration site family, member 11 antibody; Wingless-type MMTV integration site family, member 11B antibody; wnt-11 antibody; wnt11 antibody; WNT11_HUMAN antibody; wnt11b antibody
-
宿主:Rabbit
-
反應種屬:Human,Mouse
-
免疫原:Fusion protein of Human WNT11
-
免疫原種屬:Homo sapiens (Human)
-
標記方式:Non-conjugated
-
抗體亞型:IgG
-
純化方式:Antigen affinity purification
-
濃度:It differs from different batches. Please contact us to confirm it.
-
保存緩沖液:-20°C, pH7.4 PBS, 0.05% NaN3, 40% Glycerol
-
產(chǎn)品提供形式:Liquid
-
應用范圍:ELISA,IHC
-
推薦稀釋比:
Application Recommended Dilution ELISA 1:2000-1:5000 IHC 1:25-1:100 -
Protocols:
-
儲存條件:Upon receipt, store at -20°C or -80°C. Avoid repeated freeze.
-
貨期:Basically, we can dispatch the products out in 1-3 working days after receiving your orders. Delivery time maybe differs from different purchasing way or location, please kindly consult your local distributors for specific delivery time.
-
用途:For Research Use Only. Not for use in diagnostic or therapeutic procedures.
相關產(chǎn)品
靶點詳情
-
功能:Ligand for members of the frizzled family of seven transmembrane receptors. Probable developmental protein. May be a signaling molecule which affects the development of discrete regions of tissues. Is likely to signal over only few cell diameters.
-
基因功能參考文獻:
- FZD8 co-localizes and co-immunoprecipitates with Wnt-11 and potentiates Wnt-11 activation of ATF2-dependent transcription PMID: 29717114
- we found that the hypoxic environment of the perivenular zone promotes Wnt11 expression in hepatocytes, which then regulates unique gene expression via activation of the non-canonical Wnt pathway PMID: 29244788
- TGF-beta1-induced sm-alpha-actin expression is mediated by WNT-11 via RhoA activation and subsequent actin cytoskeletal remodeling. PMID: 27422998
- The positive rates of Wnt11 protein in normal esophageal epithelium tissue was 29.8% and in esophageal carcinomas tissue was 31.9%; there was no significant difference between the two groups PMID: 27628667
- Data suggest that Wnt-11 may serve as a target for cervical cancer therapy. PMID: 27034261
- The Wnt11 gene plays an important role in human mesenchymal stromal cells for enhancing the osteogenesis in an infectious environment. PMID: 26818191
- Demonstrate immunohistochemical expression of Wnt11 and BCL2A1 in complete moles and normal villi. PMID: 27386628
- Report high expression of Wnt11 in esophageal squamous cell carcinoma, which was significantly associated with AJCC stage. PMID: 26261605
- Notch1-induced WISP-1 expression appeared to be Wnt11-dependent, but Wnt1-independent PMID: 22715413
- High expression of Wnt-11 is associated with metastasis in cervical cancer. PMID: 24737009
- Data established a seven-gene (AR, ESR2, GATA3, GBX2, KRT16, MMP28 and WNT11) prognostic signature to define a subset of triple-negative breast cancer (TNBC). PMID: 23549873
- Estrogen/progesterone treatment of mature myometrial cells induced expression of WNT11 and WNT16, which remained constitutively elevated in leiomyoma tissues. PMID: 24082114
- Wnt11 mRNA expression was significantly higher in the stage I, II, III, or IV colorectal tumor tissues than in non-tumor colon. PMID: 22161723
- Wnt11 is involved in the protection of the host intestinal cells by blocking the invasion of pathogenic bacteria, suppressing inflammation, and inhibiting apoptosis. PMID: 21903761
- WNT11 emerged as a direct target of ERG. PMID: 21242973
- These observations highlight the distinct roles of WNT11 and WNT4 during the early stages of retinoic acid-induced neuronal differentiation. PMID: 21280163
- Data provide evidence for an autocrine regulatory loop involving transcriptional upregulation of WNT11 by ERRalpha and beta-cat that influences the migratory capacity of cancer cells. PMID: 20870744
- These observations suggest a novel role for Wnt11 as a tumor suppressor during hepatocarcinogenesis because loss of expression promotes the malignant phenotype via both canonical and noncanonical Wnt signaling pathways. PMID: 20103596
- These observations suggest that the increased level of Wnt-11 found in prostate cancer contributes to tumour progression by promoting neuroendocrine-like differentiation. PMID: 20219091
- WNT11 mRNA was up-regulated in four cases of colorectal adenocarcinoma, and a case of renal cell carcinoma. Up-regulation of WNT11 mRNA might play an important role in human carcinogenesis through activation of the WNT signaling pathway. PMID: 11712081
- Wnt11 stimulates proliferation, migration, cytoskeletal rearrangement, and contact-independent growth by a beta-catenin-independent mechanism PMID: 15084607
- Wnt11 promotes cardiac differentiation via the non-canonical PKC-dependent signaling pathway PMID: 15701629
- Wnt11 gene is expressed during early embryonic development and has a critical role in regulation of gastrulation movements. PMID: 15708567
- Wnt-11 promotes cell viability and is involved in coordination of key signaling pathways. PMID: 18572162
- Our study reveals an unappreciated role for noncanonical Wnt signaling in hESC specification that involves development of unique mesoderm precursors via morphogenic organization within human EBs. PMID: 19265664
顯示更多
收起更多
-
亞細胞定位:Secreted, extracellular space, extracellular matrix.
-
蛋白家族:Wnt family
-
組織特異性:Expressed in fetal lung, kidney, adult heart, liver, skeletal muscle, and pancreas.
-
數(shù)據(jù)庫鏈接:
Most popular with customers
-
-
YWHAB Recombinant Monoclonal Antibody
Applications: ELISA, WB, IHC, IF, FC
Species Reactivity: Human, Mouse, Rat
-
Phospho-YAP1 (S127) Recombinant Monoclonal Antibody
Applications: ELISA, WB, IHC
Species Reactivity: Human
-
-
-
-
-